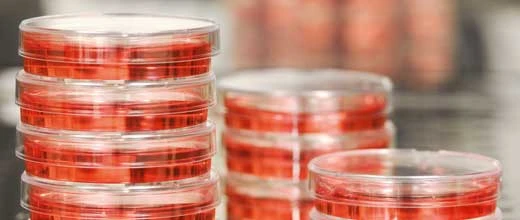
Nach 300 Prozent-Rallye bei Sygnis: Neuer Biotech-Star bietet Chance auf 146 Prozent

Biotechnologie-Aktien zählen derzeit zu den absoluten Überfliegern an der Börse. 300 Prozent innerhalb weniger Tage - solche Gewinne sind wohl nur in diesem Sektor möglich. Wie etwa mit der Aktie des DNA-Spezialisten Sygnis, die - kurz vor Weihnachten empfohlen -, Anlegern eben diesen horrenden Gewinn eingebracht hat. Jetzt bietet sich eine neue Chance. Mit einem Micro-Cap, der in den Rallye-Modus wechselt. Ausgehend vom Empfehlungskurs bietet er die Chance auf schnelle 146 Prozent. Zögern wäre fatal, denn der Kurs ist bereits angesprungen.
DER AKTIONÄR stellt im Rahmen seiner aktuellen Titelstory in Ausgabe 04/14 (jetzt sofort als digitale ePaper-Ausgabe lesen) einen Biotech-Hot-Stock vor, der wohl zu den aussichtsreichsten Titeln für das Jahr 2014 zählt. Das Papier, das über jede Menge Potenzial verfügt, eignet sich jedoch nur für risikobereite Anleger. Denn das Unternehmen bringt nur wenige Millionen Euro auf die Börsenwaage. Ein Micro-Cap also, der sich durch hohe Volatilität und somit durch heftige Kurssprünge auszeichnet. Und der Kurs ist bereits angesprungen. Wer von der Kursentwicklung profitieren möchte, sollte sich folglich nicht allzu viel Zeit mit seiner Entscheidung lassen. Um welchen Titel es sich handelt, und welche weiteren 4 Hot-Stocks im neuen Jahr auf der Siegerstraße unterwegs sein dürften, erfahren Sie in der neuen Ausgabe des AKTIONÄR, die Sie jetzt hier als digitale ePaper-Ausgabe lesen können.
Weitere Top-Themen im neuen Heft (Nr. 04/2014 steht hier für Sie als ePaper zum Abruf bereit):
- Saubere Sache: Vestas, Nordex und Gamesa konnten 2013 dreistellig zulegen. Werden die Aktien 2014 ähnlich erfolgreich abschneiden?
- Neubewertung! Ins Start-up-Portfolio dieser Beteiligungsfirma kommt richtig Schwung. Ein Wachstumstreiber ist der Boom von Videoabrufen per Smartphone.
- Wachstum auf Chinesisch: Nach einem starken zweiten Halbjahr 2013 steht der Top-Tipp Spekulativ vor einem neuen Rekordjahr - Dank China und Apple.
- Eine neue, goldene Ära: Barrick Gold hat mit Erfolg die größte Kapitalerhöhung der kanadischen Minengeschichte platziert und gleichzeitig ein teures Prestigeprojekt auf Eis gelegt. Das Unternehmen ist gut gerüstet, um die Durststrecke beim Goldpreis zu überwinden.
Profitieren auch Sie von den besten Aktien-Tipps und verpassen Sie auf keinen Fall die neue Ausgabe des AKTIONÄR (Nr. 04/2014), die hier als digitales ePaper-Magazin für Sie zum Abruf bereit steht.
Übrigens: Abonnenten haben automatisch vollen Zugriff auf die digitale Ausgabe – und zwar unabhängig davon, ob sie das klassische Abonnement (gedruckte Ausgabe + ePaper) oder das digitale Abonnement (ePaper) gewählt haben. Entscheiden auch Sie sich jetzt für ein Abonnement und profitieren sie von den vielen Vorteilen, die exklusiv nur Abonnenten zur Verfügung stehen. Unter anderem werden Sie sofort über alle Änderungen in Deutschlands erfolgreichem Aktiendepot (+1.500 Prozent seit Auflegung) per E-Mail benachrichtigt. Selbiges gilt für das erfolgreiche TSI-Depot sowie das Derivate-Depot. Zudem können Sie alle Ausgaben nicht nur online, sondern auch auf Ihrem iPad, iPhone oder Android-Gerät lesen – wann und wo Sie wollen. Entscheiden Sie sich jetzt für ein Abonnement des AKTIONÄR – Deutschlands großem Börsenmagazin. Hier gelangen Sie zur Übersichtsseite mit allen angebotenen Abonnement-Varianten.

 DER AKTIONÄR – Unsere App
DER AKTIONÄR – Unsere App

14.01.2014, 10:35
14.01.2014, 10:35


 Sofortkauf
Sofortkauf